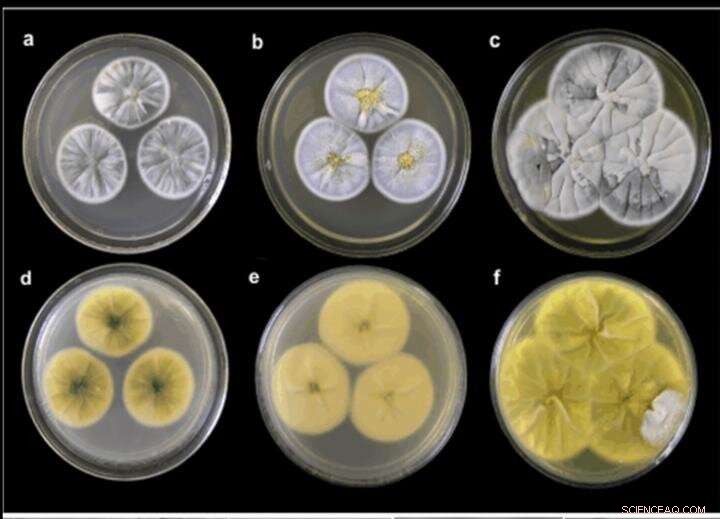
New Sea-Fungal Compounds Offer Promising Herbicidal Activity

Olesya Zhuravleva, Ph.D., Head of the Laboratory of Biologically Active Compounds, FEFU School of Natural Sciences. Credit: FEFU press office
Scientists at the Far Eastern Federal University (FEFU) and the G.B. Elyakov Pacific Institute of Bioorganic Chemistry (FEB RAS) together with German colleagues spotted six new and three already known biologically active compounds in a new strain of the fungus Penicillium piltunensein the first time it has been isolated. One compound has a pronounced anti-inflammatory activity, others have herbicidal potential, i.e., they can possibly become components of new chemicals for weed control. A related study is published in Marine Drugs.
The spotted compounds are the derivatives of aspterric acid, from which herbicidal activity was previously highlighted in a scientific report published in Nature journal. The authors of the report noted that the acid has a moderate ability to inhibit plant growth, but suggested its analogs may be more effective.
"We believe that the compounds isolated could potentially have herbicidal activity since they are the very analogs of aspterric acid, which our foreign colleagues wrote about in Nature. We have not yet been able to check how strongly these properties are expressed in the substances found, but we plan to find it out further. Worth noting—new herbicidal compounds have not been introduced onto the market for about 30 years," said Olesya Zhuravleva, Ph.D., Head of the Laboratory of Biologically Active Compounds, FEFU School of Natural Sciences.
The scientist went on to explain that one of the compounds has a pronounced anti-inflammatory activity confirmed by an experiment on macrophage cell lines of mice. In the future, new substances can be useful in developing anti-inflammatory drugs.
A new strain of the fungus Penicillium piltunense first time isolated from sea soil collected near the northeast shelf of the Sakhalin Island, The Sea of Okhotsk. Credit: FEFU
Scientists are also planning to test all the compounds obtained for antimicrobial activity. If confirmed, the compounds will also become candidates for the development of new antibiotics.
Fungi of the genus Penicillium are one of the most common fungus species on our planet. They grow both on land and in the ocean, where they are associated with seagrass, algae, soil, vertebrate and invertebrate animals.
The previously unknown strain of the fungus Penicillium piltunense KMM4648 was isolated from sea soil collected near the northeast shelf of Sakhalin Island, in the Sea of Okhotsk during a marine expedition on the "Akademik Oparin" research vessel. The strain was described by mycologists of the Laboratory of Microbiology PIBOC FEB RAS, Dr. Mikhail V. Pivkin and Dr. Natalya Kirichuk.
Subsequently, the fungal strain was investigated by researchers at the Laboratory of Biologically Active Compounds of the FEFU School of Natural Sciences, together with colleagues from the Laboratory of Microbial Metabolites of the PIBOC FEB RAS.